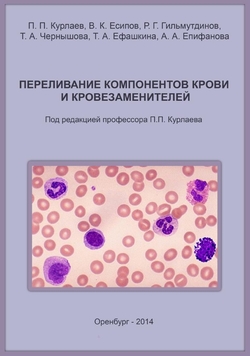

Переливание компонентов крови и кровезаменителей
Об издании
В монографии представлены сведения о групповых системах крови человека, их значении в трансфузионной практике и методах их определения. Приведена современная гемотрансфузионная тактика, базирующаяся на отказе от переливания цельной крови в пользу проведения гемокомпонентной терапии. Дана классификация компонентов и препаратов крови, кровезаменителей, и определены показания к их применению. Описаны возможные осложнения переливания компонентов крови, их диагностика, профилактика и лечение. Изложены основные кровесберегающие технологии, и освещена проблема донорства. Издание предназначено для врачей всех специальностей, применяющих переливание крови, ее препаратов и кровезаменителей, а также может быть полезной для студентов, клинических интернов и ординаторов медицинских вузов РФ.
Библиографическая запись
Переливание компонентов крови и кровезаменителей / П.П. Курлаев [и др.].. — Оренбург : Оренбургская государственная медицинская академия, 2014. — 336 c. — ISBN 978-5-91924-062-4. — Текст : электронный // Цифровой образовательный ресурс IPR SMART : [сайт]. — URL: https://www.iprbookshop.ru/51483.html (дата обращения: 28.03.2026). — Режим доступа: для авторизир. пользователей
РЕКОМЕНДУЕМ К ПРОЧТЕНИЮ
Окороков А.Н.
(Медицинская литература, Профобразование)
Окороков А.Н.
(Медицинская литература, Профобразование)
Окороков А.Н.
(Медицинская литература, Профобразование)
Богун В.В.
(Ай Пи Ар Медиа)
Абрашкина Е.Д., Антонова Е.Г., Арзамасцева Н.В., Бабанская А.С., Бесшапошный М.Н., Бирюкова Т.В., Васильева О.Н., Водянников В.Т., Глойдман И.М., Григорьева Л.А., Гупалова Т.Н., Джикия К.А., Джикия М...
(Ай Пи Ар Медиа)

.jpg)








.jpg)

